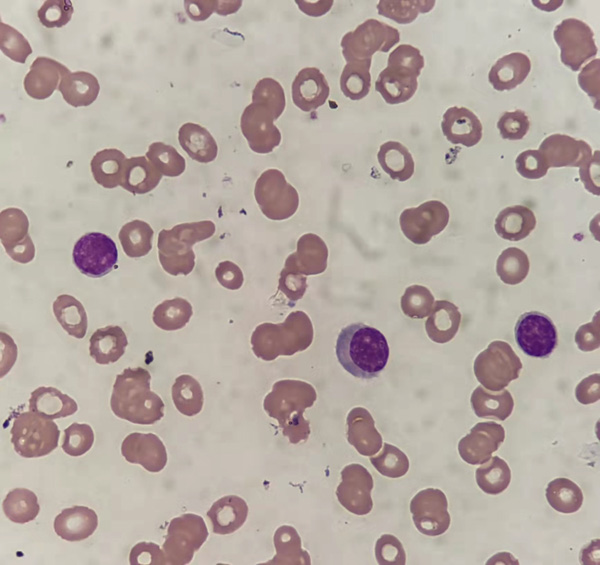

提起醫(yī)學(xué)檢驗(yàn)科,可能很多人都會(huì)說(shuō),不就是化驗(yàn)室嗎?其實(shí)遠(yuǎn)遠(yuǎn)沒(méi)有那么簡(jiǎn)單,現(xiàn)代醫(yī)學(xué)檢驗(yàn)中的“檢”是檢測(cè)、檢查,重點(diǎn)在分析中的質(zhì)量控制,“驗(yàn)”則是指校驗(yàn)、驗(yàn)證,重點(diǎn)在分析后的質(zhì)量控制,發(fā)現(xiàn)分析前產(chǎn)生的問(wèn)題,檢驗(yàn)結(jié)果的解釋、進(jìn)一步檢查的建議都是其業(yè)務(wù)范圍。
近年來(lái)血液系統(tǒng)疾病發(fā)病率逐年增高,其診斷隨著免疫學(xué)、細(xì)胞遺傳學(xué)、分子生物學(xué)的發(fā)展而快速發(fā)展。目前以WHO(世界衛(wèi)生組織)提倡的MICM(細(xì)胞形態(tài)學(xué)、免疫學(xué)、細(xì)胞遺傳學(xué)、分子生物學(xué))綜合診斷為主,而血細(xì)胞形態(tài)學(xué)仍是最基礎(chǔ)的手段,也是柳州市人民醫(yī)院醫(yī)學(xué)檢驗(yàn)科骨髓細(xì)胞室的主要檢驗(yàn)項(xiàng)目,力求精準(zhǔn)診斷,及早提供血液系統(tǒng)疾病方面的信息,為臨床診治提供直接而充足的依據(jù)。
輾轉(zhuǎn)就醫(yī) 檢驗(yàn)探明病因
近日藍(lán)先生在外院檢查考慮為多發(fā)性骨髓瘤,抱著對(duì)柳州市人民醫(yī)院的信任,轉(zhuǎn)至我院血液內(nèi)科。入院后,醫(yī)生非常重視藍(lán)先生的病情,特地聯(lián)系檢驗(yàn)科骨髓細(xì)胞室關(guān)注藍(lán)先生的骨髓涂片及血涂片。

檢驗(yàn)科骨髓細(xì)胞室檢驗(yàn)人員在血涂片鏡下發(fā)現(xiàn)一類胞體小、呈圓形、胞核居中、胞漿量少且偏藍(lán)色的細(xì)胞。此類細(xì)胞既不像典型淋巴細(xì)胞,也不像典型漿細(xì)胞。結(jié)合骨髓涂片細(xì)胞形態(tài),考慮該類細(xì)胞為腫瘤性漿細(xì)胞,其比例已達(dá)到漿細(xì)胞白血病的診斷標(biāo)準(zhǔn)。此時(shí)骨髓細(xì)胞室考慮漿細(xì)胞白血病的結(jié)論與外院診斷多發(fā)性骨髓瘤結(jié)果存在出入。為進(jìn)一步明確藍(lán)先生的病因,骨髓細(xì)胞室建議臨床做針對(duì)漿細(xì)胞白血病做進(jìn)一步檢驗(yàn)。不出所料,免疫學(xué)、細(xì)胞遺傳學(xué)及分子生物學(xué)檢查結(jié)果與骨髓細(xì)胞室形態(tài)學(xué)報(bào)告相符。
漿細(xì)胞白血病(plasma cell leukemia,PCL)是一種罕見(jiàn)的侵襲性漿細(xì)胞惡性腫瘤,惡性程度高,預(yù)后差,早發(fā)現(xiàn)早治療方能提高患者生存率。該病診斷的關(guān)鍵點(diǎn)及難點(diǎn)在于外周血細(xì)胞及時(shí)準(zhǔn)確發(fā)現(xiàn)漿細(xì)胞及其比例,稍有偏差就容易誤判。骨髓細(xì)胞室醫(yī)務(wù)人員憑借專業(yè)技術(shù)水平和嚴(yán)謹(jǐn)?shù)拈喥瑧B(tài)度,及時(shí)提供準(zhǔn)確的診斷,對(duì)臨床及時(shí)明確疾病病因和患者的診治中起到了關(guān)鍵作用。
表面風(fēng)平浪靜 鏡下險(xiǎn)象環(huán)生
江女士因淋巴結(jié)腫大來(lái)到柳州市人民醫(yī)院就診,經(jīng)淋巴結(jié)活檢確診為淋巴瘤,在治療之前需通過(guò)骨髓涂片及骨髓活檢來(lái)確定是否存在骨髓侵犯。骨髓活檢結(jié)果未發(fā)現(xiàn)淋巴瘤細(xì)胞,但在骨髓涂片見(jiàn)有個(gè)別細(xì)胞形態(tài)異常且多樣,經(jīng)多人閱片校對(duì),最終診斷該類細(xì)胞為淋巴瘤細(xì)胞,給予臨床意見(jiàn)為考慮淋巴瘤骨髓侵犯。對(duì)極少量淋巴瘤細(xì)胞侵犯骨髓時(shí),骨髓活檢組織常難鑒別其形態(tài)特點(diǎn),檢出率低,針對(duì)這一難點(diǎn),骨髓涂片卻可以解決。

涂片可清晰分辨細(xì)胞的形態(tài),卻非常考驗(yàn)閱片人對(duì)淋巴瘤細(xì)胞形態(tài)的掌握,骨髓細(xì)胞室檢驗(yàn)人員克服了技術(shù)困難,揪出真相。后續(xù)患者骨髓免疫分型結(jié)果與骨髓細(xì)胞形態(tài)學(xué)一致,明確為淋巴瘤骨髓侵犯。這例骨髓細(xì)胞形態(tài)學(xué)報(bào)告及時(shí)向臨床提供患者骨髓真實(shí)信息,保障患者得到及時(shí)準(zhǔn)確診治,提高了治療效果。
張女士6天前于外院分娩,分娩前血常規(guī)檢查各項(xiàng)指標(biāo)正常。產(chǎn)后出現(xiàn)流血,血常規(guī)檢查提示貧血及血小板進(jìn)行性減少,尿色濃茶樣改變,為進(jìn)一步診治轉(zhuǎn)入我院。入院后出現(xiàn)頭暈、少語(yǔ)等意識(shí)障礙。

骨髓細(xì)胞室閱血涂片見(jiàn)較多破碎紅細(xì)胞,考慮為血栓性血小板減少性紫癜(TTP),立即以危急值形式報(bào)告臨床,并建議做針對(duì)性檢查。

經(jīng)檢查結(jié)果確定了TTP的診斷,通過(guò)血漿置換治療后,張女士病情好轉(zhuǎn)出院。TTP是一種臨床少見(jiàn)的、致命的血栓性微血管病,涉及多個(gè)系統(tǒng),病情復(fù)雜且進(jìn)展迅速,死亡率高,但如能及早診斷及治療,能大大提高生存率。血涂片細(xì)胞形態(tài)對(duì)及早診斷TTP作用大,能一眼定乾坤。
“隨著醫(yī)學(xué)的快速發(fā)展,檢驗(yàn)科與臨床聯(lián)系更加緊密。加強(qiáng)檢驗(yàn)科與臨床之間的交流,強(qiáng)化有效溝通,才能為臨床治療提供科學(xué)、準(zhǔn)確的診療依據(jù)。”醫(yī)學(xué)檢驗(yàn)科主任唐石伏介紹,在保證檢驗(yàn)結(jié)果準(zhǔn)確的基礎(chǔ)上,為臨床提供合理的結(jié)果解釋,根據(jù)異常檢驗(yàn)線索提出需要增加的檢驗(yàn)需求,為臨床診治提供有力支持,才能實(shí)現(xiàn)檢驗(yàn)工作更好地服務(wù)于臨床,服務(wù)于患者。

每當(dāng)診斷罕見(jiàn)或疑難病例后,醫(yī)學(xué)檢驗(yàn)科骨髓細(xì)胞室均及時(shí)整理病例資料,在國(guó)內(nèi)血液病整合診斷討論群進(jìn)行分享討論,通過(guò)與專家交流溝通,提高專科技術(shù)水平和積累疑難病例的經(jīng)驗(yàn),同時(shí),骨髓細(xì)胞室人員還將專家討論的意見(jiàn)與我院血液科醫(yī)生進(jìn)行分享學(xué)習(xí),通過(guò)一個(gè)病例的診斷討論、分享討論再到總結(jié)學(xué)習(xí),助力臨床的同時(shí),時(shí)刻提高自身能力,為廣大患者提供更優(yōu)質(zhì)準(zhǔn)確的醫(yī)學(xué)檢驗(yàn)服務(wù)。
柳州市人民醫(yī)院醫(yī)學(xué)檢驗(yàn)科骨髓細(xì)胞室是從事血細(xì)胞形態(tài)學(xué)的醫(yī)學(xué)檢驗(yàn)實(shí)驗(yàn)室,現(xiàn)有4名檢驗(yàn)人員,其中副主任技師1人、主治醫(yī)師1人,主管技師2人,3人具有檢驗(yàn)醫(yī)師資格,在讀研究生3人。

配備多臺(tái)高級(jí)生物顯微鏡,開(kāi)展骨髓細(xì)胞形態(tài)學(xué)、外周血細(xì)胞形態(tài)學(xué)及肺泡灌洗液形態(tài)學(xué)等項(xiàng)目檢查。有全套細(xì)胞形態(tài)學(xué)染色項(xiàng)目,可進(jìn)行各類常見(jiàn)血液疾病診斷,并輔助診斷一些少見(jiàn)病例,診斷結(jié)果與臨床符合率高。注重報(bào)告質(zhì)量,采取雙人閱片、分級(jí)閱片、疑難病例討論及病例追蹤等工作模式,注重MICM診斷。2021年參與臨床疑難病例會(huì)診13次,2021年完成造血干細(xì)胞移植項(xiàng)目形態(tài)學(xué)標(biāo)本95份。具備規(guī)培生、實(shí)習(xí)生帶教實(shí)力,全程實(shí)施一對(duì)一教學(xué)模式,教學(xué)質(zhì)量佳,為全區(qū)各級(jí)醫(yī)療機(jī)構(gòu)培養(yǎng)了大批血液學(xué)檢驗(yàn)專業(yè)人才。團(tuán)隊(duì)人員技術(shù)水平高,年輕成員有擔(dān)任白求恩精神研究會(huì)檢驗(yàn)醫(yī)學(xué)分會(huì)理事和細(xì)胞形態(tài)學(xué)檢驗(yàn)診斷專業(yè)委員會(huì)委員。

近年來(lái)陸續(xù)在廣西寄生蟲(chóng)防治技術(shù)競(jìng)賽獲得團(tuán)體二等獎(jiǎng)、血液病診斷論壇形態(tài)學(xué)大賽中獲二等獎(jiǎng)、白求恩精神研究會(huì)廣西檢驗(yàn)醫(yī)學(xué)專業(yè)委員會(huì)第一屆細(xì)胞形態(tài)學(xué)大賽團(tuán)體一等獎(jiǎng)。